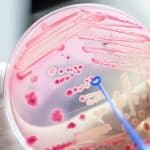
ICAR-IISS Microbiology

Home Search
NABI - search results
If you're not happy with the results, please do another search
Biotecnika Times – Newsletter 18.03.2021 – MoHFW NIB Biologists Opening, Ferrero Rocher Food
Biotecnika Times - MoHFW NIB Biologists Opening, Ferrero Rocher Food
MoHFW National Institute of Biologicals Hiring For Bench Biologists Openings
NIB Bench Biologists Jobs – Biotech/Biochem/Mol...
NIPGR JRF / SRF & Project Associate Recruitment – Applications Invited
NIPGR JRF / SRF & Project Associate Recruitment - Applications Invited
NIPGR JRF / SRF & Project Associate Recruitment - Applications Invited. MSc/MTech Life Science/...
NIPGR Research Associate Vacancy For PhD Life Science Candidates
NIPGR Research Associate Vacancy For PhD Life Science Candidates
NIPGR Research Associate Vacancy For PhD Life Science Candidates. PhD Life Science/ Biotechnology/ Molecular Biology &...
Biotecnika Times – Newsletter 02.03.2021 – Govt FDA Food Safety Officer Recruitment, NBRC
Biotecnika Times - Govt FDA Food Safety Officer Recruitment, NBRC
Govt FDA Food Safety Officer Recruitment – Applications Invited
Govt FDA Food Safety Officer Recruitment –...
Member TOS Page
Terms of Services
OVERVIEW
This website is operated by BioTecNika Store. Throughout the site, the terms “we”, “us” and “our” refer to BioTecNika Store. BioTecNika Store...
Biotecnika Times – Newsletter 18.02.2021 – Govt Food Analyst Recruitment 2021, CSIR-IICB
Biotecnika Times - Govt Food Analyst Recruitment 2021, CSIR-IICB
Govt Food Analyst Recruitment 2021 & Rs. 60,000 pm Salary - Apply Online
Govt Food Analyst Recruitment...
Novel CRISPR Technology Targets The Human Genome’s Complex Code
Novel CRISPR technology targets the human genome's complex code
CRISPR technology has revolutionized biology research and industry with its remarkable capabilities and potentials.
A new genome-editing...
Biotecnika Times – Newsletter 28.01.2021 – Govt Silk Board Recruitment, Siemens Hiring, Women
Biotecnika Times - Govt Silk Board Recruitment, Siemens Hiring, Women
Government Silk Board Seri Biotech Research Lab Recruitment
Government Silk Board Seri Biotech Research Lab Recruitment....
NIPGR Research Fellow & Project Associate Jobs – Applications Invited
NIPGR Research Fellow & Project Associate Jobs - Applications Invited
NIPGR Research Fellow & Project Associate Jobs - Applications Invited. MSc/MTech Life Science/ Biochem /Biotech...
RASTH 2021: International Conference By SRM Research Institute
RASTH 2021: International Conference By SRM Research Institute
RASTH 2021: International Conference By SRM Research Institute. International Conference On Recent Advances in Applied Sciences,...
NIPGR Life Sciences PhD Research Associate Recruitment
NIPGR Life Sciences PhD Research Associate Recruitment
NIPGR Life Sciences PhD Research Associate Recruitment. PhD Life Sciences Jobs. NIPGR PhD Jobs. NIPGR Latest Jobs. Interested...
Biotecnika Times – Newsletter 19.01.2021 – Bharat Serums & Vaccines Hiring, CDFD Rs. 75,000...
Biotecnika Times - Bharat Serums & Vaccines Hiring, CDFD Rs. 75,000 pm
CDFD National Genomics Core Project Recruitment With Rs. 75,000 pm Salary
CDFD Genomics Jobs...
NIPGR Project Scientist Job Openings – Applications Invited
NIPGR Project Scientist Job Openings - Applications Invited
NIPGR Project Scientist Job Openings - Applications Invited. MTech/PhD Life Sciences/Biotechnology/Bioinformatics Jobs. NIPGR MTech/PhD Jobs. NIPGR Latest...
Biotecnika Times – Newsletter 05.01.2021 – TIFR GS2021 Exam Alert, Food Safety Officer
Biotecnika Times - TIFR GS2021 Exam Alert, Food Safety Officer
TIFR GS2021 Exam Alert : Applications Open For MSc / Int.PhD / PhD Admissions
The notification...
ICAR-IISS Microbiology Senior Research Fellow Job Opening
ICAR-IISS Microbiology Senior Research Fellow Job Opening
ICAR-IISS Microbiology Senior Research Fellow Job Opening. MSc Microbiology Senior Research Fellow Vacancy. SRF Microbiology Job. Interested and...